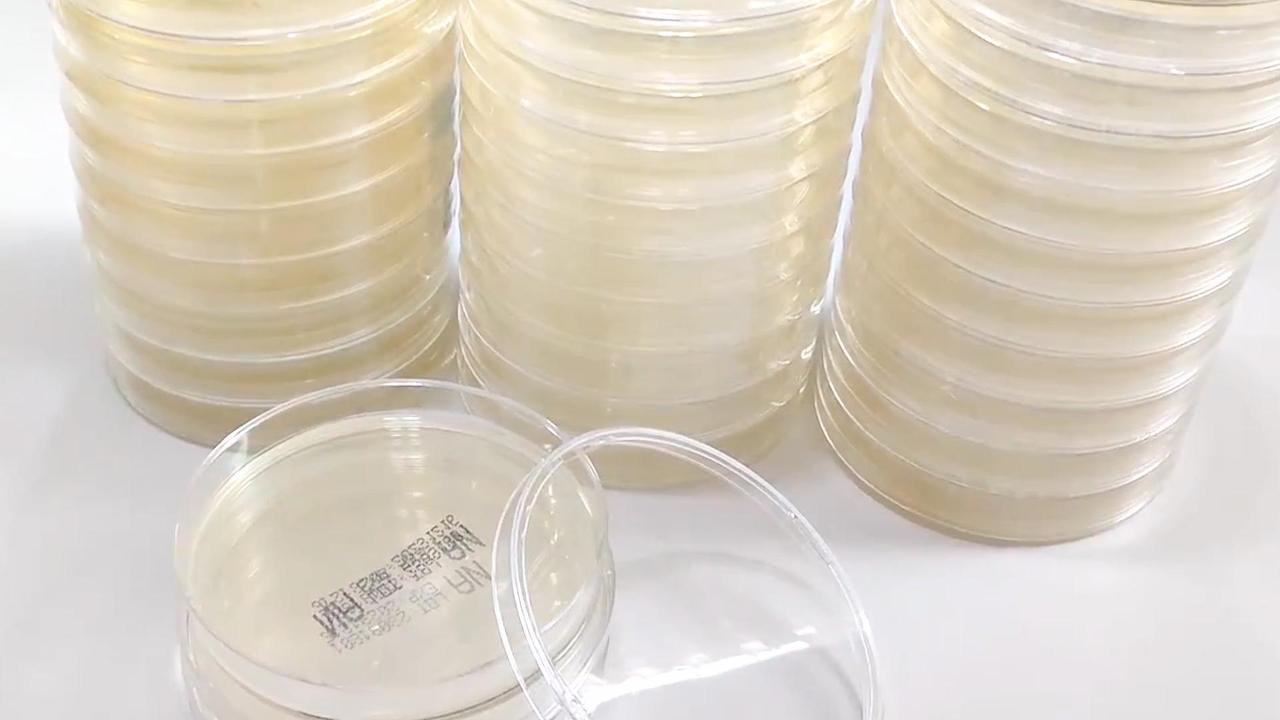

ການປົດລັອກທ່າແຮງຂອງທາດອາຫານທີ່ມີຄວາມຫມາຍກາງສໍາລັບການທົດສອບດ້ານຈຸລິນຊີ
ທາດອາຫານທີ່ມີທາດອາຫານຂະຫນາດກາງແມ່ນພື້ນຖານໃນການທົດສອບ microbiological, ສະເຫນີຄວາມຫນ້າເຊື່ອຖືແລະຄວາມຄ່ອງແຄ້ວໃນການເຮັດຄວາມປອດໄພດ້ານອຸດສະຫະກໍາ, ຢາ, ແລະຕິດຕາມເຄື່ອງສໍາອາງ. ຂະຫນາດກາງທີ່ໄດ້ຮັບການຍອມຮັບຢ່າງກວ້າງຂວາງນີ້ເຮັດໃຫ້ສານອາຫານທີ່ຈໍາເປັນເພື່ອສະຫນັບສະຫນູນການເຕີບໃຫຍ່ຂອງຈຸລິນຊີທີ່ບໍ່ແມ່ນໄວ, ເຮັດໃຫ້ມັນເປັນເຄື່ອງມືທີ່ມີຄ່າໃນທົ່ວໂລກ.
ທາດອາຫານ agar ຂະຫນາດກາງແມ່ນຂະຫນາດກາງທີ່ມີຈຸດປະສົງທົ່ວໄປທີ່ຖືກອອກແບບມາເພື່ອປູກຝັງເຊື້ອແບັກທີເຣຍແລະເຊື້ອລາທີ່ກວ້າງຂວາງ. ດ້ວຍການປະກອບທີ່ສົມດຸນຂອງມັນ, ມັນຮັບປະກັນຜົນໄດ້ຮັບທີ່ສອດຄ່ອງແລະຖືກຕ້ອງໃນສະຖານະການທົດສອບທີ່ຫລາກຫລາຍ, ຈາກການຕິດຕາມຕົວຢ່າງດ້ານສິ່ງແວດລ້ອມໃນການຄວບຄຸມດ້ານຄຸນນະພາບໃນການຜະລິດໃນການຜະລິດ.
ການນໍາໃຊ້ສານອາຫານເສີມຂະຫນາດກາງແມ່ນກົງໄປກົງມາ. ຕົວຢ່າງຂອງຕົວຢ່າງແມ່ນ inoculated ໃສ່ພື້ນຜິວຂອງ Agar, incubated ໃນອຸນຫະພູມທີ່ຕ້ອງການ, ແລະກວດເບິ່ງສໍາລັບການເຕີບໂຕຂອງຈຸລິນຊີ. ຂະບວນການນີ້ຊ່ວຍໃຫ້ຫ້ອງທົດລອງສາມາດກໍານົດການປົນເປື້ອນແລະຮັບປະກັນຄວາມສອດຄ່ອງກັບມາດຕະຖານຄວາມປອດໄພ.
Babio Baby Biotechnology, ຜູ້ຜະລິດຊາວຈີນທີ່ເຊື່ອຖືໄດ້, ມີສື່ມວນຊົນວັດທະນະທໍາທີ່ມີຄຸນນະພາບສູງທີ່ມີຄວາມຕ້ອງການສະເພາະຂອງຫ້ອງທົດລອງ. ຂະຫນາດກາງຂອງທາດອາຫານຂອງ Nutrient ຂອງພວກເຮົາແມ່ນຜະລິດໃນ 100 ສະພາບແວດລ້ອມທີ່ສະອາດ 100 ຊັ້ນໂດຍໃຊ້ເຄື່ອງດູດຝຸ່ນອາກາດທີ່ເຫມາະສົມໃນການຮັບປະກັນການເປັນຫມັນ. ທຸກໆຊຸດທີ່ໄດ້ຮັບການກວດສອບຄຸນນະພາບທີ່ເຂັ້ມງວດເພື່ອຕອບສະຫນອງມາດຕະຖານໂລກ.
ການສຶກສາທີ່ຜ່ານມາສະແດງໃຫ້ເຫັນວ່າ Baby Agar's Agar ໄດ້ສົ່ງຜົນລະບຸທາດ microtent ທີ່ຖືກຕ້ອງແລະອັດຕາທີ່ມີປະສິດຕິພາບສູງເກີນ 98% ໃນການຕັ້ງຄ່າຫ້ອງທົດລອງທີ່ຄວບຄຸມໄດ້ 98%. ນີ້ເຮັດໃຫ້ມັນເປັນທາງເລືອກທີ່ຕ້ອງການສໍາລັບນັກຄົ້ນຄວ້າແລະຜູ້ຊ່ຽວຊານດ້ານການຄວບຄຸມຄຸນນະພາບ.

ໃນຖານະເປັນຜູ້ຜະລິດສື່ມວນຊົນດ້ານວັດທະນະທໍາ microbial, Babio BabyBio ອີງໃສ່ປະເທດຈີນ, ພວກເຮົາຊ່ຽວຊານໃນການໃຫ້ຜະລິດຕະພັນທີ່ມີນະວັດສະສົງ, ມີຄຸນນະພາບສູງ, ລວມທັງອາຫານເສີມທີ່ມີທາດອາຫານ, ໃຫ້ລູກຄ້າທົ່ວໂລກ. ຢ້ຽມຢາມພວກເຮົາທີ່www.babiocorp.comເພື່ອຮຽນຮູ້ເພີ່ມເຕີມກ່ຽວກັບການສະເຫນີຂອງພວກເຮົາ.
ເລືອກ Babio Baby BiTechnology ສໍາລັບຄວາມຫນ້າເຊື່ອຖື, ມີປະສິດທິພາບ, ແລະມີຜົນກະທົບທີ່ມີຄ່າໃຊ້ຈ່າຍໃນການທົດສອບ microgiological.